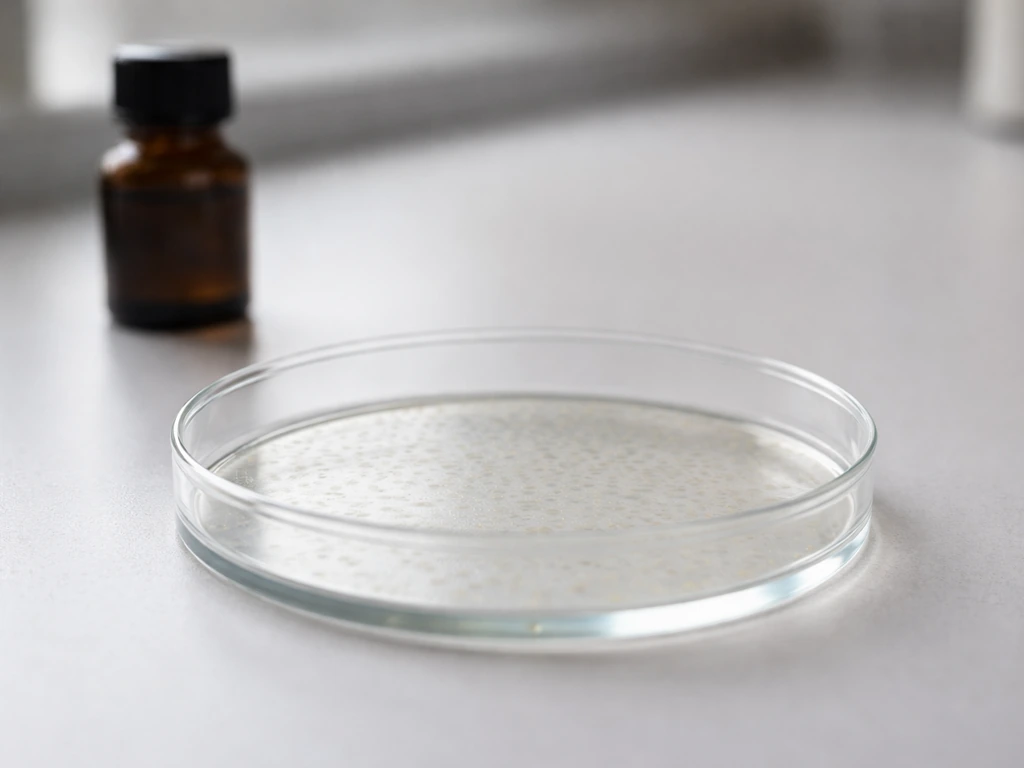
Minimal photo of an anonymous lab culture fading as a dark nutrient solution bottle sits nearby

Growth is one of those words that sounds simple until you try to explain it precisely. Whether you're watching a seedling push through soil, a crystal form in a saltwater jar, or a tumor expand in a tissue culture dish, the core question is always the same: what is actually happening, step by step, and what determines whether growth speeds up, slows down, or stops? This guide works through all of that, but first, we need to pin down what "it" actually is, because the answer changes significantly depending on what's doing the growing.
How Does It Grow: Biological and Crystal Growth Explained

What does "it" refer to? Pinning down the type of growth
"It grows" can mean very different things. Here are the major categories worth distinguishing:
- Single cells: bacteria, yeast, individual human cells increasing in size before dividing
- Multicellular organisms: animals, fungi, or plants building tissues, organs, and body plans from coordinated cell activity
- Plants specifically: growth driven by meristematic tissue, photosynthesis, and cell expansion
- Fungi: including the branching networks of hyphae and the spread of mycelium through a substrate
- Crystals: growth by adding material at surfaces from a supersaturated solution, with no biology involved
- Geological formations: stalactites, rock layers, and mineral deposits accumulating over long timescales via chemical and physical processes
Biological growth and crystal/geological growth follow fundamentally different rules. Biological growth is driven from the inside: genes switch on, cells divide, and organisms execute a developmental program. Crystal and geological growth are driven from the outside: material deposits onto a surface when physical or chemical conditions allow. Both are constrained by transport and energetics, but the mechanisms are worlds apart. The sections below cover both, so you can find the explanation that fits your specific "it."
The core biological engine: cell division and mitosis

At the heart of biological growth is one deceptively simple act: one cell becomes two. Every organism you can see with the naked eye got there through repetition of that act, coordinated across billions of cells. The mechanism is mitosis, and it runs on a tightly regulated schedule called the cell cycle.
The cell cycle has distinct phases: growth phases (G1 and G2), a DNA synthesis phase (S), and mitosis itself (M). What keeps it honest are three major checkpoints, positioned near the end of G1, at the G2-to-M transition, and during metaphase. These checkpoints are not passive gates. They are active surveillance systems that weigh "go" and "stop" signals. At the G1 checkpoint, the cell must prove it has the resources and intact DNA needed to commit to replication. If something is wrong, progression halts. If DNA damage is severe enough, that halt can become permanent, triggering apoptosis (programmed cell death).
Fungi grow by a related but structurally distinct process. Instead of rounding up and dividing like animal cells, fungal hyphae extend at their tips, a process called apical growth. If you want to understand how hyphae grow in detail, the tip-extension mechanism is worth studying on its own, because it explains a lot about how fungi colonize substrates so efficiently.
Growth needs inputs: energy, nutrients, water, and raw materials
No growth happens for free. Every dividing cell, expanding plant, or depositing crystal requires a steady supply of the right inputs. For biological systems, these fall into four categories.
- Energy: Cells run on ATP. Without enough ATP, the chemical reactions that build proteins, replicate DNA, and move molecules simply stop. Most ATP is generated through cellular respiration, specifically chemiosmosis, which accounts for roughly 90% of ATP production during glucose metabolism. No energy supply, no growth.
- Nutrients and building materials: Cells need amino acids to make proteins, nucleotides to copy DNA, lipids to build membranes, and minerals for enzymes and structural molecules. Plants pull carbon from CO2 and minerals from the soil. Animals get these through food. Crystals need dissolved ions from a surrounding solution.
- Water: Biological cells depend on water as a solvent for nearly every reaction. Plant cell expansion is driven largely by water uptake increasing turgor pressure inside the cell wall. Ions and nutrients travel through organisms dissolved in water.
- The right chemical and thermal environment: Enzymes operate within specific temperature ranges. Many biological reactions require particular pH levels or ion concentrations. Homeostasis, maintained by negative feedback loops that counteract deviations from set points, keeps these conditions stable enough for growth to proceed.
For crystals, the equivalent of "nutrients" is dissolved solute in a supersaturated solution. Supersaturation is a non-equilibrium state where the concentration of dissolved material exceeds what the solution can hold at equilibrium under a given temperature and pressure. That excess is the driving force for crystal growth: material deposits onto a surface until the system converges back toward equilibrium. As it does, the growth rate slows. This is exactly analogous to the way a plant slows its growth as soil nutrients are depleted.
Why things can't just keep growing: physical limits and geometry

Here is one of the most counterintuitive facts in biology: a cell cannot simply grow larger indefinitely, even if it has plenty of nutrients. The reason is geometry. As a cell gets bigger, its volume increases faster than its surface area. Double the cell's diameter, and the volume grows by a factor of eight while the surface area only quadruples. Since nutrients and oxygen enter (and waste leaves) through the surface, a larger cell struggles to supply its larger interior through diffusion alone.
The numbers make this concrete. Oxygen diffusion in tissue is effectively limited to about 100 micrometers from the nearest blood vessel. Cells or tissues beyond that distance become hypoxic. In multicellular tumor spheroids growing in culture, central hypoxia appears by day 4, an anoxic core develops by day 6, and by day 15 a distinct necrotic center has formed. The outer shell keeps proliferating while the core dies, because diffusion simply cannot reach it. An avascular solid tumor hits a diffusion-limited size on the order of a few millimeters before it must recruit new blood vessels (via VEGF signals from its hypoxic core) to grow further.
Crystals face an analogous transport constraint: the rate of growth equals the rate at which solute can be supplied to the growing surface. When supply is slow, growth is slow, regardless of how much material exists in the bulk solution.
From genes to tissues to organs: how development programs growth
A single fertilized egg cell contains the full instruction set for building an entire organism, yet different cells end up as neurons, liver cells, or skin. How? The answer is positional information, delivered by morphogens: signaling molecules that form concentration gradients across a developing tissue. Cells read the local morphogen concentration and, at specific threshold levels, switch on different genes and adopt different identities. This is the core logic of the French flag model, where a single gradient produces distinct zones based on where cells fall relative to concentration thresholds.
Real morphogen gradients operate at remarkable precision. BMP gradients can span from a single cell diameter to several hundred micrometers, forming over timescales from 30 minutes to 24 hours. In neural tube development, a SHH (Sonic Hedgehog) gradient is precise enough to define specific tissue boundaries at the subdomain level. Gene regulatory networks (GRNs) then take those initial positional cues and translate them into tissue-level decisions: which cells proliferate, which differentiate, which form the boundary of an organ. This is why a fruit like a fig develops with such precise internal architecture, and if you're curious about that specific case, looking at how a fig grows from flower to fruit is a beautiful illustration of developmental programming at work.
It's also worth noting that different organisms have evolved different growth strategies for the same basic developmental goals. Date palms, for instance, grow from a single terminal meristem, which means damage to that growing tip can halt the entire plant's upward growth, a stark contrast to the distributed meristematic zones in many other plants. And apple trees rely on a carefully timed hormonal cascade to move from vegetative growth into flowering and fruiting, showing how developmental programs are as much about timing as they are about spatial patterning.
Why growth slows and stops
Growth never just runs out of steam randomly. There are specific, well-characterized reasons it decelerates or halts, and they operate at different scales.
Resource depletion and feedback regulation
As a population of cells or organisms consumes nutrients, the supply dwindles and growth slows. Negative feedback loops regulate this at the cellular level: when a cell detects adequate product, signals feed back to reduce production. This is the same principle that keeps your body temperature from spiraling out of control. Negative feedback loops maintain the internal steady states that make growth possible in the first place, but they also act as governors that prevent runaway expansion.
Cell-cycle arrest, apoptosis, and senescence
At the molecular level, growth arrest is executed through two major pathways. The p53-p21 axis can inhibit the cyclin-dependent kinases (CDKs) that drive cell-cycle progression, causing arrest at the G1/S boundary. If DNA damage is irreparable, p53 can trigger apoptosis, eliminating the cell rather than allowing it to pass on errors. Separately, the p16-RB pathway enforces senescence, a permanent growth-arrested state where the cell stays alive but no longer divides. Both pathways are responses to stress signals including DNA damage, telomere shortening, and oncogene activation.
Equilibrium limits in crystals and geology

Crystal growth stops when the solution reaches saturation, because the thermodynamic drive to deposit material disappears. At the solubility product (Ksp) equilibrium, crystal faces can no longer accumulate new material. Geological formations follow similar logic but at vastly longer timescales: deposition slows when chemical gradients diminish, when temperature shifts, or when source material is exhausted. The network of branching threads that makes up mycelium shows a biological parallel to this: hyphal tips stop extending when they run out of substrate to colonize or when the local environment becomes inhospitable.
Growth patterns over time: exponential start, logistic finish
One of the most useful mental models for understanding growth is the distinction between exponential and logistic growth. Early on, when resources are abundant and constraints haven't kicked in, growth looks exponential: each generation produces more growing units, which produce still more. The rate feels like it accelerates. But real-world environments impose carrying capacities, whether those are nutrient limits, physical space, oxygen diffusion limits, or thermodynamic equilibria. As the growing system approaches those limits, per-capita growth rate falls, and the growth curve flattens into a characteristic S-shape (sigmoid curve).
| Growth Phase | What drives it | What it looks like | When it ends |
|---|---|---|---|
| Early exponential | Abundant resources, few constraints | Rapid acceleration, doubling times feel constant | When resource or space limits begin to bite |
| Transitional | Resources thinning, regulation increasing | Growth continues but decelerates | When feedback loops and transport limits dominate |
| Logistic plateau | Near carrying capacity, strong feedback | Growth nearly zero, maintenance dominates | System holds steady or begins decline |
| Decline / cessation | Resource exhaustion, senescence, equilibrium | Net loss or zero net growth | Death, dormancy, or thermodynamic equilibrium |
This pattern shows up everywhere. Melanoma spheroids in culture grow exponentially for roughly the first 10 days before the necrotic core, hypoxic shell, and proliferating outer rim create a stable (and self-limiting) structure. A sourdough starter doubles quickly in a fresh jar of flour and water, then slows as acids accumulate and sugars run low. A stalactite adds material rapidly when the cave environment is rich in dissolved calcite, then slows as the drip rate or ion concentration drops.
Biological vs. non-biological growth side by side
| Feature | Biological growth (cells/organisms) | Crystal growth | Geological growth |
|---|---|---|---|
| Driven by | Internal genetic programs + metabolism | External supersaturation gradient | Chemical deposition, pressure, temperature |
| Energy source | ATP from cellular respiration or photosynthesis | Thermodynamic free energy of supersaturation | Geochemical and geothermal energy |
| Growth site | Throughout (cell division) or at tips (hyphae, roots) | At crystal surface/faces | At depositional surfaces or zones |
| Key constraint | Diffusion, surface-area-to-volume, nutrient supply | Solute supply rate, approach to Ksp | Ion flux, temperature, pressure, timescale |
| Growth stops when | Senescence, apoptosis, resource depletion, feedback | Solution reaches saturation equilibrium | Source material, gradient, or conditions exhausted |
| Timescale | Minutes (bacteria) to decades (trees) | Hours to years | Thousands to millions of years |
Troubleshooting your specific case: what to actually check

If you're trying to understand why something is or isn't growing the way you expected, here is a practical sequence of questions to work through.
- Identify the growth type: Is this biological (cells, organisms, fungi, plants) or physical (crystal, mineral, geological deposit)? This determines which mechanisms are relevant.
- Check the inputs first: Is energy available? Are nutrients, water, or dissolved ions present in sufficient quantity? Deficiency in any single input can be the entire explanation.
- Look at the transport geometry: How large is the growing structure? Is the center being reached by diffusion? If the structure exceeds ~100 micrometers in tissue without a vascular supply, expect a hypoxic or depleted core.
- Check the environment: Is temperature, pH, or ion concentration within the range the system needs? For crystals, is the solution still supersaturated, or has it equilibrated?
- Ask whether regulation is stopping it: For biological systems, is the growth-arrest machinery (p53-p21, p16-RB, checkpoints) being triggered by stress or damage? Is feedback signaling calling for a halt?
- Map where you are on the growth curve: Is this an early exponential phase, a transitional phase approaching limits, or a plateau? Early slowdowns are often input problems; late slowdowns are often constraint or feedback problems.
- Consider the developmental program: For organisms, is growth halted because a developmental program has completed, not because something has gone wrong? Many organisms stop growing at precise sizes because their gene regulatory networks tell them to.
The single most common mistake people make when thinking about growth is assuming that more of one input will solve a growth problem. Usually, growth is limited by its scarcest resource, what ecologists call the limiting factor. Adding more of what's already abundant does nothing. Find the actual bottleneck, and you find the lever that matters.
FAQ
How do I tell which rules apply when I ask “how does it grow”?
Start by identifying what “it” refers to, then pick the mechanism category. If it depends on cell division, expect cell-cycle limits and diffusion/oxygen constraints. If it depends on a surface accumulating material, expect transport limits (how fast solute reaches the surface) and thermodynamic limits (approaching saturation). If you mix categories, you will predict the wrong bottleneck.
Does growth always start exponentially, and when should I expect it to stop being exponential?
It can be, but only when each new unit creates more favorable conditions and no constraint is yet limiting. Exponential growth typically holds early, before diffusion limits, nutrient depletion, waste buildup, or saturation kicks in. Later, the curve usually becomes logistic as the effective growth rate per cell declines.
If something grows more slowly, how can I find the real limiting factor quickly?
Look for the limiting factor, not just “more nutrients.” For cell-based growth, common bottlenecks are oxygen delivery (often diffusion-limited), waste removal, surface area constraints, or cell-cycle checkpoint arrest from DNA damage. For crystal growth, common bottlenecks are solute supply rate to the interface and how close the solution is to saturation.
Why doesn’t increasing nutrients always make cells (or tissues) grow faster?
Doubling a cell’s diameter is misleading because nutrient and oxygen exchange scale with surface area, while metabolic demand scales more like volume. As cells get larger, diffusion and transport become insufficient, so growth slows or stops even when external nutrients seem plentiful.
Are “growth stopping” mechanisms the same in cells and in crystals?
They are different. In biological growth, checkpoints can halt the cell cycle temporarily or permanently (senescence), and severe DNA damage can remove the cell via apoptosis. In crystal growth, “arrest” is often thermodynamic, growth ceases when saturation is reached and the drive to deposit disappears.
In a tissue or tumor that has a necrotic core, does the whole structure stop growing?
Not necessarily. A multicellular solid can stop expanding in the interior while the outside still proliferates, because the core becomes hypoxic or anoxic due to diffusion limits. In those cases, overall size may still increase, but viable growth depends on whether a new blood supply or equivalent transport pathway develops.
What inputs matter besides “food” for biological growth to continue?
Replication and expansion require multiple inputs, so “nutrient-only” thinking often fails. Biological growth depends on energy and building blocks plus conditions that keep checkpoints passing (intact DNA, manageable stress). Even with abundant substrates, persistent stress can produce arrest via p53-p21 or senescence via p16-RB.
If morphogen gradients are disrupted, what kind of growth or patterning defects should I expect?
Yes, but the direction is specific. In development, morphogens set positional identity by concentration thresholds, and then gene regulatory networks translate those into cell behaviors. Changes in the gradient profile or timing can shift where boundaries form or which cell types differentiate.
Why might adding more solute not speed crystal growth?
More starting material does not guarantee faster growth for crystals. If growth is supply-limited, adding bulk solute without improving transport to the interface may not help. If growth is saturation-limited, reducing supersaturation or changing temperature/pressure can change the driving force and slow deposition.
How do transport limits change the timing and shape of growth curves?
Transport constraints are not just about whether growth is “possible,” they determine the shape and timing of the growth curve. For example, diffusion limits can create a hypoxic shell and then a necrotic center, producing self-limiting behavior even if nutrients are present externally.
What’s a reliable way to test whether diffusion or saturation is limiting in my system?
A practical check is to measure growth while changing one variable at a time and see which lever shifts the curve. If growth tracks with oxygen or diffusion conditions, oxygen delivery is likely limiting. If it tracks with supersaturation or ion concentration at the interface, deposition thermodynamics or solute supply is likely limiting.
Why does growth sometimes speed up briefly and then slow down or reverse?
Growth can become non-monotonic, for instance, temporary acceleration followed by plateau or decline if inhibitory signals accumulate, waste builds up, or checkpoints activate. In cell systems, inhibitors like acids in sourdough or stress responses from DNA damage can alter dynamics over time.
What Controls When and How Fast Cells Grow and Divide
Learn what controls cell division timing and speed: checkpoints, signals, resources, DNA damage, stress, and failure lea


